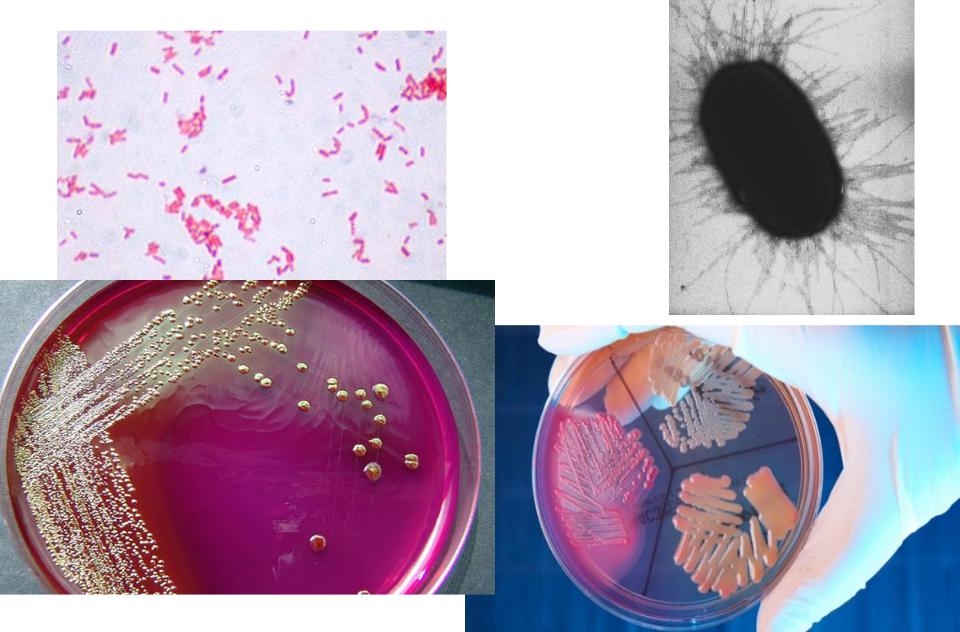
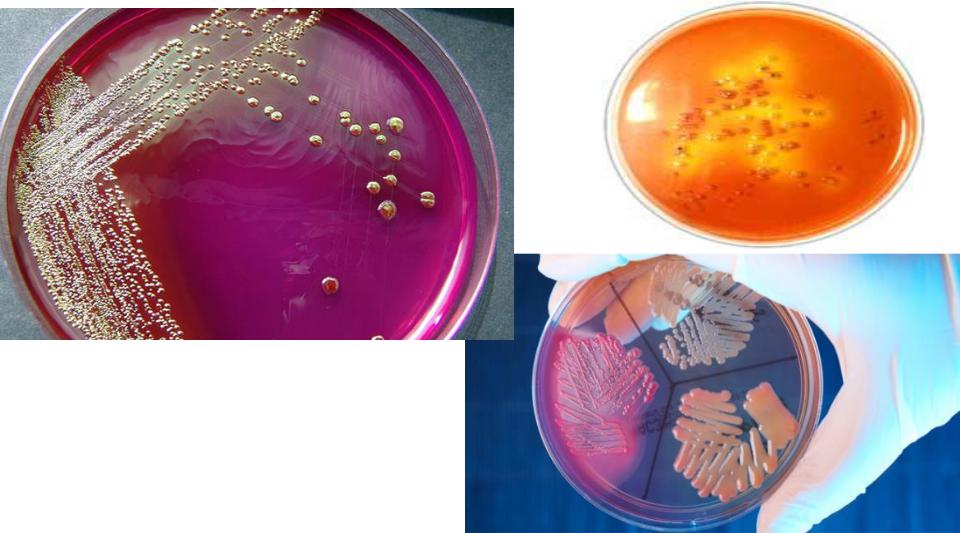

Материал: 11. Общая характеристика энтеробактерий. Эшерихии
Семейство Enterobacteriaceae
Род Escherichia

Морфология и физиология
Культуральные признаки

В 1885 году немецкий врач Теодор Эшерих выделил из кишечника детей бактерии, которые он назвал Bacterium coli commune.
С 1958 года род Escherichia
признан типовым родом семейства
Enterobacteriaceae.
Типовой вид – E. coli, сравнительно редко при различных поражениях выделяют E. fergusonii, E. hermannii, E. vulneris.
Антигены
•171 вариант О-антигенов (О1-О171),
•57 вариантов Н-антигенов (Н1-Н57) и
•более 90 вариантов поверхностных (капсульных) К-антигенов.
•Антигенная характеристика диареегенных Е. coli включает в себя номера О- и Н- антигенов, например, О55:Н6; О157:Н7;
•О-антиген (или ОК) - серогруппа, E. сoli О26: К60
(В6),
•Н-антиген - ее серовариант E. сoli О26: К60 (В6):
Н2
•Всего в список диареегенных Е. coli
включено 43 О-серогруппы и 57 ОНсеровариантов